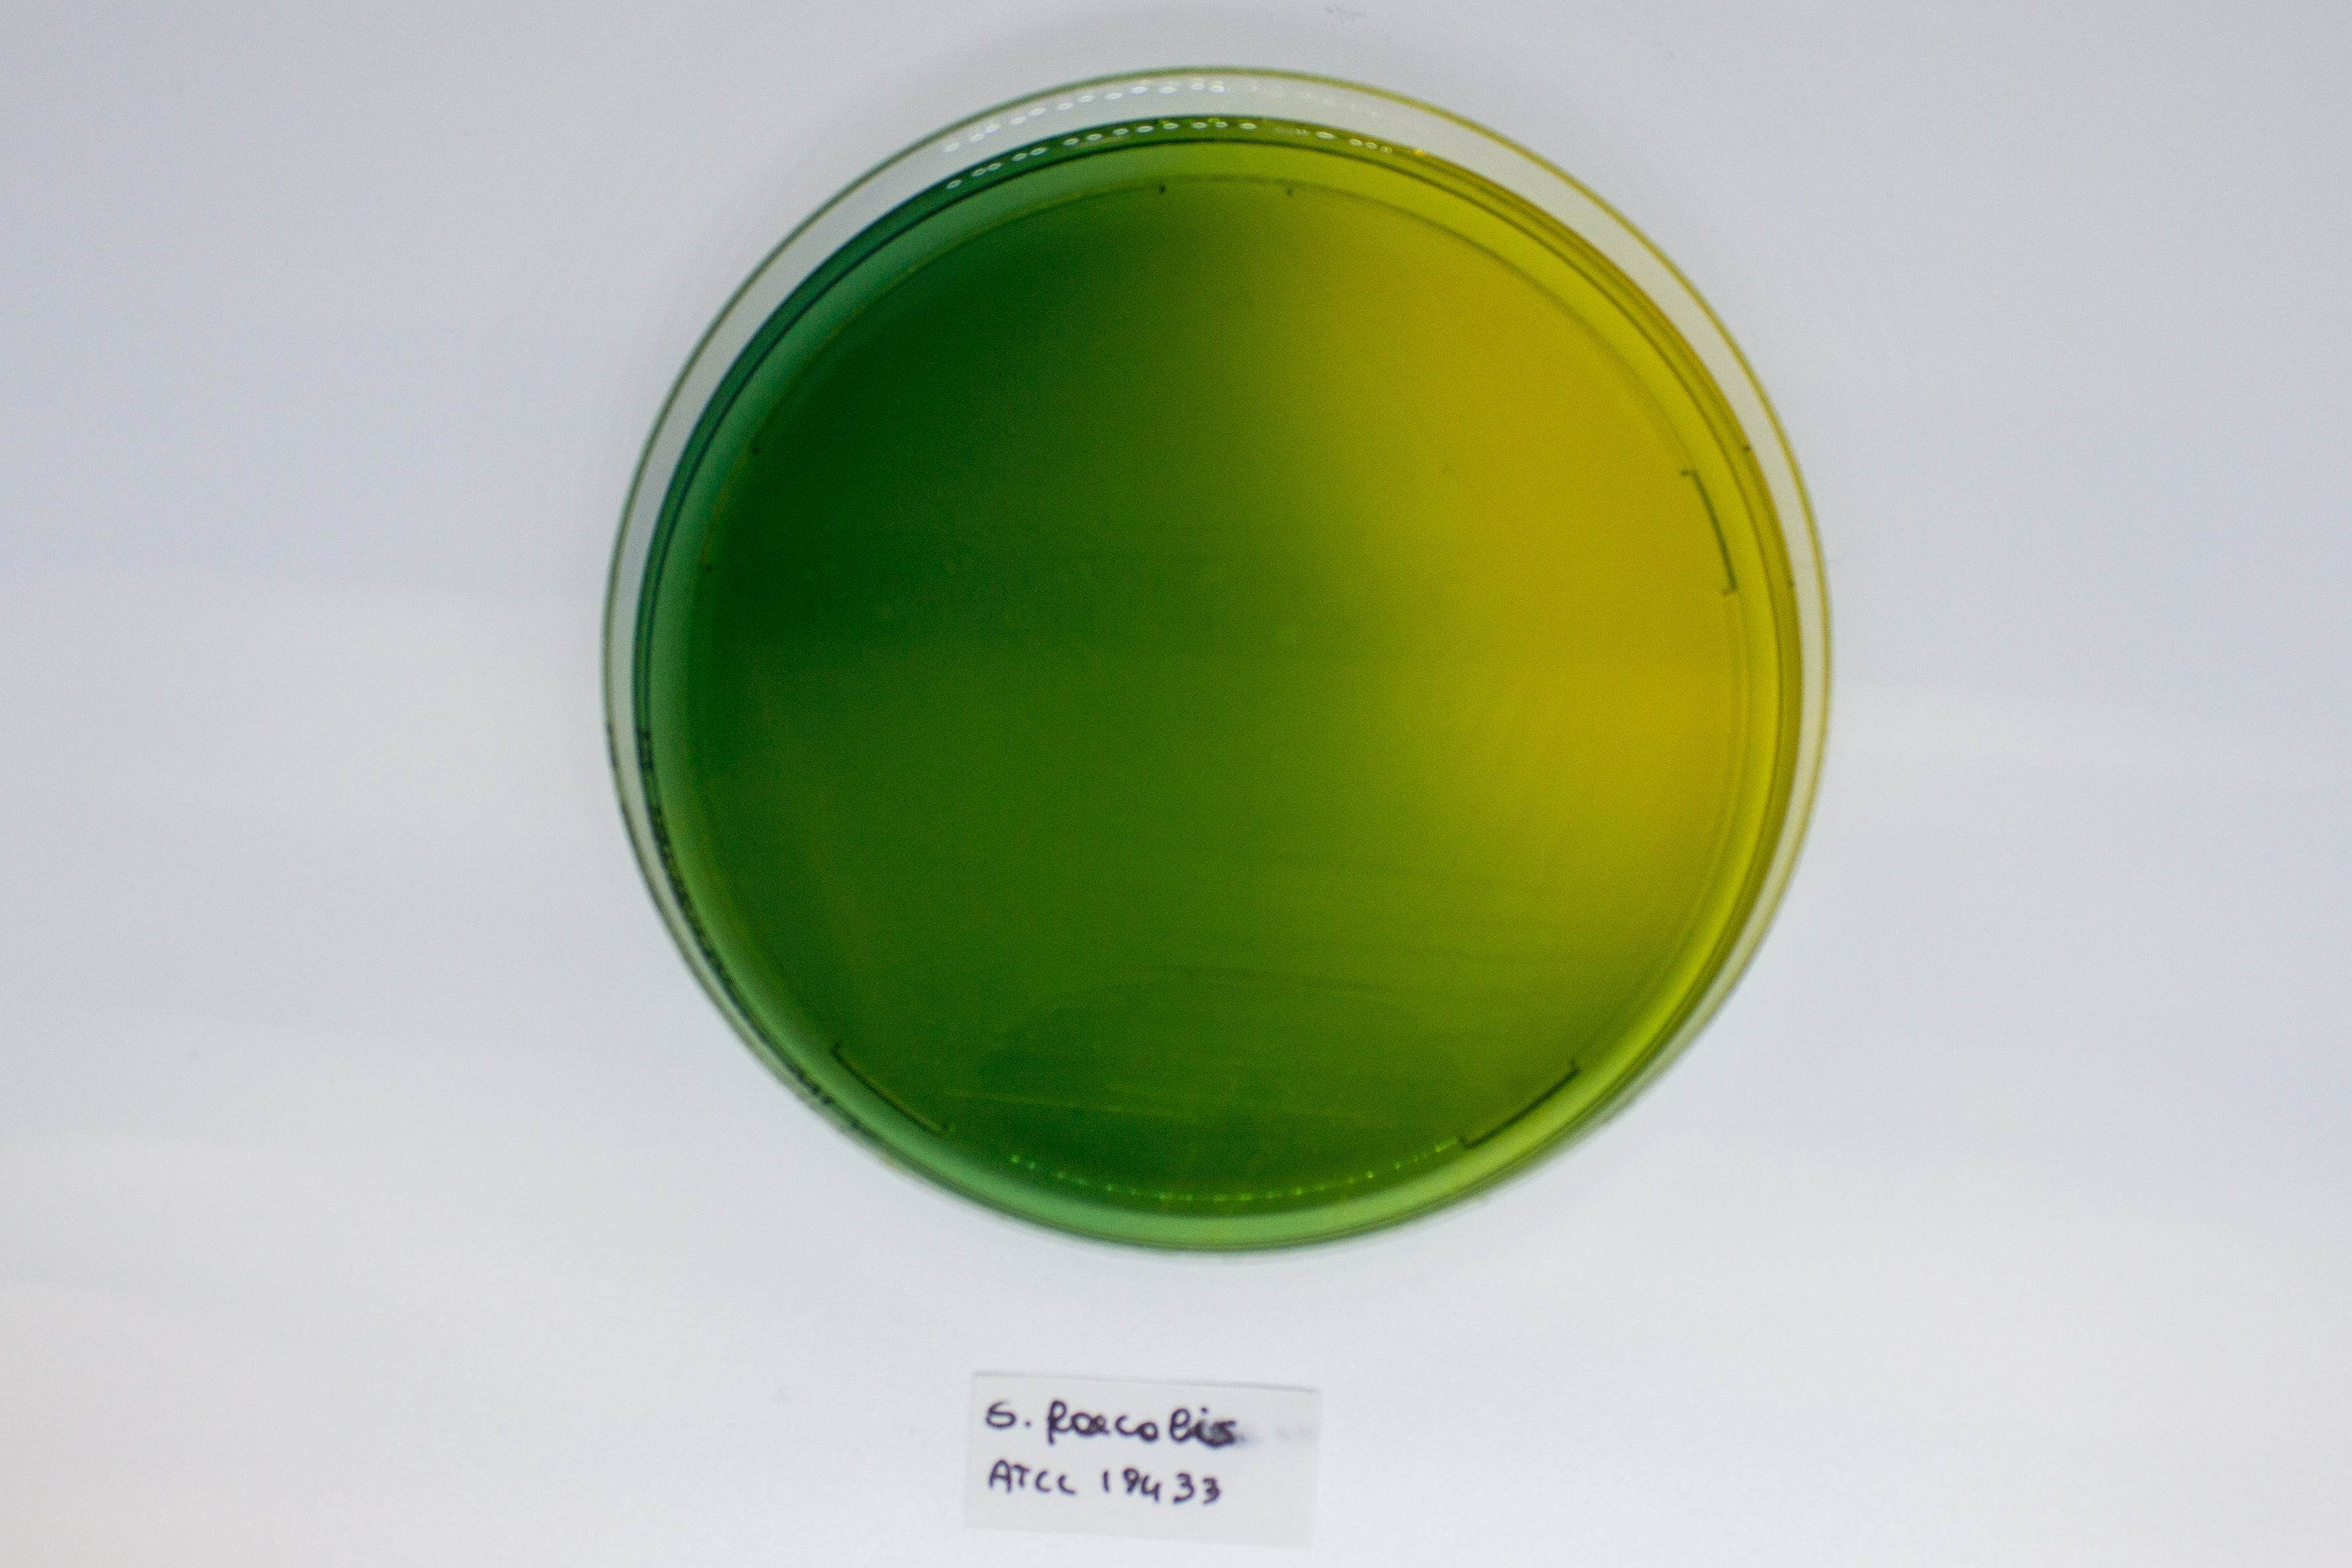
WURTZ Lactose Agar - Kormay Biomedicals store

Liofilchem
Showing 1105 - 1128 of 1140 products
Display
View


Liofilchem
Water Detect Enterococci 100 mL (tubes) - For Microbiology Lab Testing
Sale price$186.00 CAD
Filters (0)